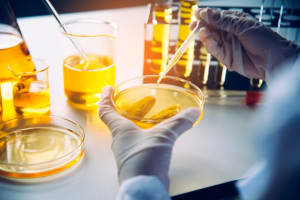
store/s/bf7f7e5f-3641-4e57-9c8b-d133ff518635.jpg

Santand´er Escape Room
C. Isaac Peral, 33, 39008 Santander, Cantabria, Spain
Experiences
![El Proyecto Científico de la Doctora Noresmo [The Scientific Project of Dr. Noresmo]](https://res.cloudinary.com/mortyapp/image/upload/c_limit,w_260/f_auto/v1/store/s/bf7f7e5f-3641-4e57-9c8b-d133ff518635.jpg)
- Escape room
- IRL
2-6
60 mins
Medium
- Escape room
- IRL
![Expedición Zero [Expedition Zero]](https://res.cloudinary.com/mortyapp/image/upload/c_limit,w_260/f_auto/v1/store/s/8c902435-8110-4b49-82d4-8018f1e4750d.jpg)
![Fantásticos Animales en Hogwarts[Fantastic Animals at Hogwarts]](https://res.cloudinary.com/mortyapp/image/upload/c_limit,w_260/f_auto/v1/store/s/69e3a8ed-379a-48a1-bc1f-f2223dad331f.jpg)
- Escape room
- IRL
2-6
75 mins
Medium
- Escape room
- IRL
![Invitación a la Escuela de Magia [Invitation to Magic School]](https://res.cloudinary.com/mortyapp/image/upload/c_limit,w_260/f_auto/v1/store/s/3933bb33-279c-40fa-af3c-50d290e7eefc.jpg)
- Escape room
- IRL
2-12
60 mins
Easy
- Escape room
- IRL

![Yucatán: El Último Templo [Yucatan: The Last Temple]](https://res.cloudinary.com/mortyapp/image/upload/c_limit,w_260/f_auto/v1/store/s/350e4b1f-82b6-426d-914d-7f5f9b3eef88.jpg)
![Expedición Zero [Expedition Zero]](https://res.cloudinary.com/mortyapp/image/upload/c_limit,w_576/f_auto/v1/store/s/8c902435-8110-4b49-82d4-8018f1e4750d.jpg)
Expedición Zero [Expedition Zero]
- Escape room
- IRL

Portus Victoriae
- Escape room
- IRL
![Yucatán: El Último Templo [Yucatan: The Last Temple]](https://res.cloudinary.com/mortyapp/image/upload/c_limit,w_576/f_auto/v1/store/s/350e4b1f-82b6-426d-914d-7f5f9b3eef88.jpg)
Yucatán: El Último Templo [Yucatan: The Last Temple]
- Escape room
- IRL
About this location
Santand´er Escape Room offers an exciting range of escape room experiences located at C. Isaac Peral, 33, 39008 Santander, Cantabria, Spain. Adventure seekers can immerse themselves in thrilling narratives such as "Yucatán: El Último Templo," where the quest is to unveil the secrets of a hidden temple. Players can also join "Expedición Zero" to unravel the mystery of a lost expedition in the Valley of the Kings, assist in "El Proyecto Científico de la Doctora Noresmo," or search for the Niffler in "Fantásticos Animales en Hogwarts." Additionally, the challenge of "Portus Victoriae" allows participants to test their skills in ancient Roman settings.
Parking facilities are conveniently available, making it easier for visitors to enjoy their escape room adventures without the hassle. Whether seeking thrills, teamwork, or just a fun outing, Santand´er Escape Room provides engaging activities for all.
![El Proyecto Científico de la Doctora Noresmo [The Scientific Project of Dr. Noresmo]](https://res.cloudinary.com/mortyapp/image/upload/c_limit,w_576/f_auto/v1/store/s/bf7f7e5f-3641-4e57-9c8b-d133ff518635.jpg)
![Fantásticos Animales en Hogwarts[Fantastic Animals at Hogwarts]](https://res.cloudinary.com/mortyapp/image/upload/c_limit,w_576/f_auto/v1/store/s/69e3a8ed-379a-48a1-bc1f-f2223dad331f.jpg)
![Invitación a la Escuela de Magia [Invitation to Magic School]](https://res.cloudinary.com/mortyapp/image/upload/c_limit,w_576/f_auto/v1/store/s/3933bb33-279c-40fa-af3c-50d290e7eefc.jpg)